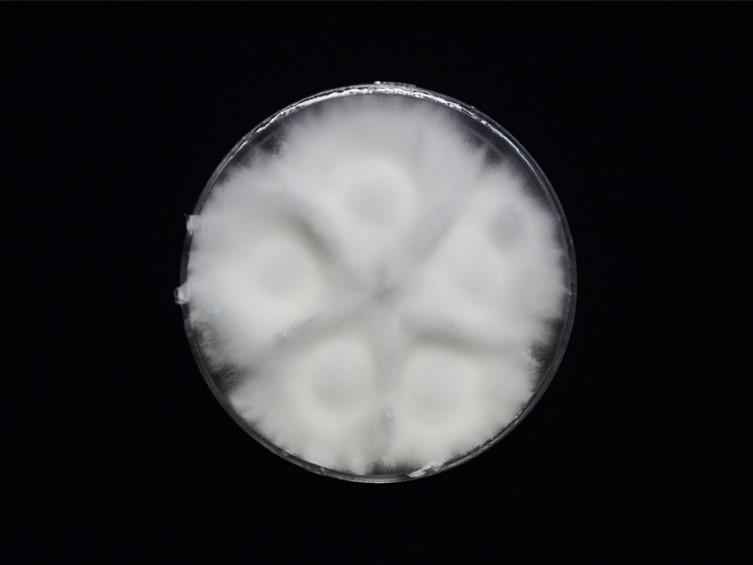

Holotype:
THAILAND, Phitsanulok Province, Ban Phaothai Community Forest, 5 Nov. 2015, K. Tasanathai, S. Mongkolsamrit, A. Khonsanit, W. Noisripoom, D. Thanakitpipattana, holotype BBH 42744, ex-type living culture BCC 79252.
Habitat:
Buried in the ground.
Host:
Lepidoptera pupa.
Description:
 Stroma on Lepidoptera pupa cylindrical, solitary, simple, 10 mm long, 1-2 mm wide, white to cream. Rhizoids flexuous, arising from the pupa of Lepidoptera, ca 8 mm long under the ground. Fertile part terminal, discoid, ovoid, 2 mm long, 2 mm wide, white to creamy.
Stroma on Lepidoptera pupa cylindrical, solitary, simple, 10 mm long, 1-2 mm wide, white to cream. Rhizoids flexuous, arising from the pupa of Lepidoptera, ca 8 mm long under the ground. Fertile part terminal, discoid, ovoid, 2 mm long, 2 mm wide, white to creamy.  Perithecia semi-immersed, ordinal in arrangement, ovoid to obclavate with protruding apices, 603-640 × 275-300 μm.
Perithecia semi-immersed, ordinal in arrangement, ovoid to obclavate with protruding apices, 603-640 × 275-300 μm.  Asci cylindrical, 235-462.5 × 2-3 μm, apical cap prominent, 2-2.5 μm wide.
Asci cylindrical, 235-462.5 × 2-3 μm, apical cap prominent, 2-2.5 μm wide.  Ascospores hyaline, filiform, whole, multi-septate, 222.5-360 × 1 μm. Conidia cylindrical, 2.5-4 × 1 μm, seen as
Ascospores hyaline, filiform, whole, multi-septate, 222.5-360 × 1 μm. Conidia cylindrical, 2.5-4 × 1 μm, seen as  microcyclic sporulation of the ascospores on glass slide. Asexual morph not seen in nature.
microcyclic sporulation of the ascospores on glass slide. Asexual morph not seen in nature.
Culture characteristics:
Colonies on PDA attaining a diam of 25 mm in 14 d, white, cottony, high mycelial density, reverse cream. Hyphae smooth-walled, hyaline, 1–1.5 μm diam, conidia and reproductive structure not observed.
Colonies on PDA attaining a diam of 25 mm in 14 d, white, cottony, high mycelial density, reverse cream. Hyphae smooth-walled, hyaline, 1–1.5 μm diam, conidia and reproductive structure not observed.
Reference:
Mongkolsamrit S, Khonsanit A, Thanakitpipattana D, et al. (2020). Revisiting Metarhizium and the description of new species from Thailand. Studies in Mycology 95: 171–251.
DOI: https://doi.org/10.1016/j.simyco.2020.04.001Species |
Strain |
Compound |
Pubchem CID |
Biological activity |
Reference |
|---|
|
Strain |
ITS | LSU | RPB1 | TEF1 |
|---|---|---|---|---|
| BCC 79252 | MN781914 | MN781829 | MN781736 | MN781682 |
| BCC 79267 | MN781915 | MN781826 | MN781735 | - |